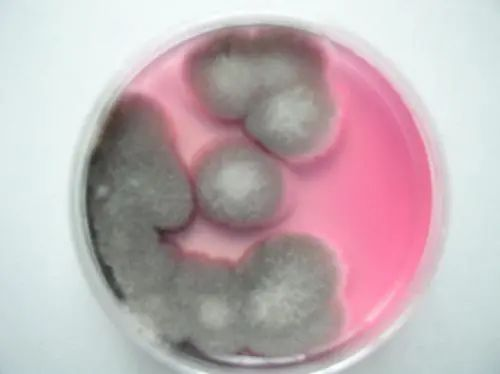
霉菌检测培养基
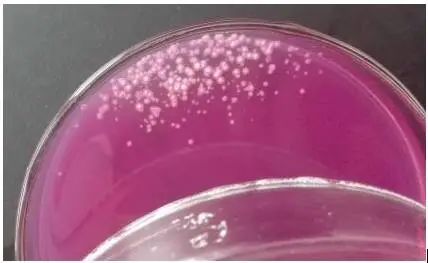
霉菌培养基

GB4789.15标准中霉菌培养容易污染问题解决方法!
发布时间:2025-05-09 浏览次数:1295
很多小伙伴在后台给小编留言,在采用国标检测霉菌是容易污染培养箱,培养箱污染了怎么处理?污染的原因到底有哪些?
小编今天就和大家一起分析一下这个问题!
GB 4789.15-2016 相比GB 4789.15-2010,最大的区别就在于对平皿的培养方式。2016版的国标在5.2中规定:“琼脂凝固后,正置平板,置28℃±1℃培养箱中培养,观察并记录培养至第5d的结果。”
其实针对这一条,需要注意两点:
第一,是需要对平板进行观察的,不能直接培养至第5天计数,因为霉菌的特殊性,在培养过程中会产生大量孢子,导致整个平板蔓延。因此,在培养后的第2天开始,就要对平板进行观察,并计数典型菌落,而这样的观察在之后每一天都应该进行,直至培养第5天。
第二,就是正置培养。这一点是16版国标与旧版最大的区别,10版之前的国标都是倒置培养的。而按照新国标进行正置培养后,很多朋友都遇到了平板被霉菌污染的问题,比如图中的情况,这是什么原因呢?
大家很容易误以为这是因为正置培养导致的,其实不然。造成这种情况的原因有很多种,可能有培养箱环境污染,平皿冷凝水污染,操作环境污染、培养基问题等等,只是正置培养让这些问题更容易显现。这些问题都该如何解决呢?
污染原因与解决措施
一、培养箱环境污染
很多实验室培养霉菌采用的是专用的霉菌培养箱,所以培养箱空间里会有大量的霉菌孢子。而平皿的盖和底是有一定缝隙的,尤其是玻璃平皿缝隙还是比较大的,正置培养中,孢子会向上飞扬通过缝隙落到平板的培养基上,导致污染。细心地实验猿可能发现,污染的菌落大部分都是在平皿边缘生长的。用一次性塑料平皿来培养,污染的概率就会小很多,因为一次性塑料平皿的盖和底之间的缝隙相比之下是比较小的。因此培养箱环境中的孢子可能会是主要污染源。
这样一来,解决的方法就应该是对培养箱进行杀菌。可以考虑用紫外线杀一下菌,同时辅助消毒剂擦拭的方法,常用消毒剂比如75%酒精和新洁尔灭等,应该注意的是,这样的杀菌操作也是需要经常进行的,因为霉菌的孢子是十分难清除的,而每次培养可能又会引进新的污染源,可以考虑每周进行两次,保证培养环境无污染源。
二、平皿冷凝水污染
正置培养过程中,若是平皿的上盖有泠凝水,在培养过程中冷凝水滴落到培养基上,也极容易造成菌落蔓延,平皿污染。因此在培养之前,一定要保证平皿干燥,可以把平皿放在37℃的环境里烘干,烘干之后再进行培养,就会避免这个原因造成的污染。
三、操作环境和培养基的污染
因为无菌室里可能也会因为灭菌效果不理想造成污染。小编之前工作的实验室,操作台使用紫外线灭菌,经常就会灭菌不彻底有孢子污染,尤其是在进行过霉菌的相关检测之后。所以在进行过霉菌检测之后,适当的增长灭菌时间,可能会达到比较理想的效果。另外,为了彻底解决无菌室空间孢子污染的问题,可以购买安装臭氧发生器,通过紫外线+臭氧的双重消毒模式,效果就十分理想了。
大家如果还是想验证一下究竟是什么原因造成的污染,这里提供一个简单的验证试验方法:在正常检测的环境中倒一组空白平皿,将这些平皿分为AB两组,其中A组用有充足氧气的自封袋将平皿封好,B组不封,均放置在培养箱中正置培养。若是A组B组均有霉菌生长,则需要考虑培养基污染或者操作环境的污染;若是A组不生长霉菌而B组生长,则需要考虑是培养箱内的环境污染。通过这个小试验,可以基本上确定污染源,然后针对污染源进行相应的处理。
说明:转载只为分享目的,如有侵权或不愿小编转载发布请联系删除,谢谢!






